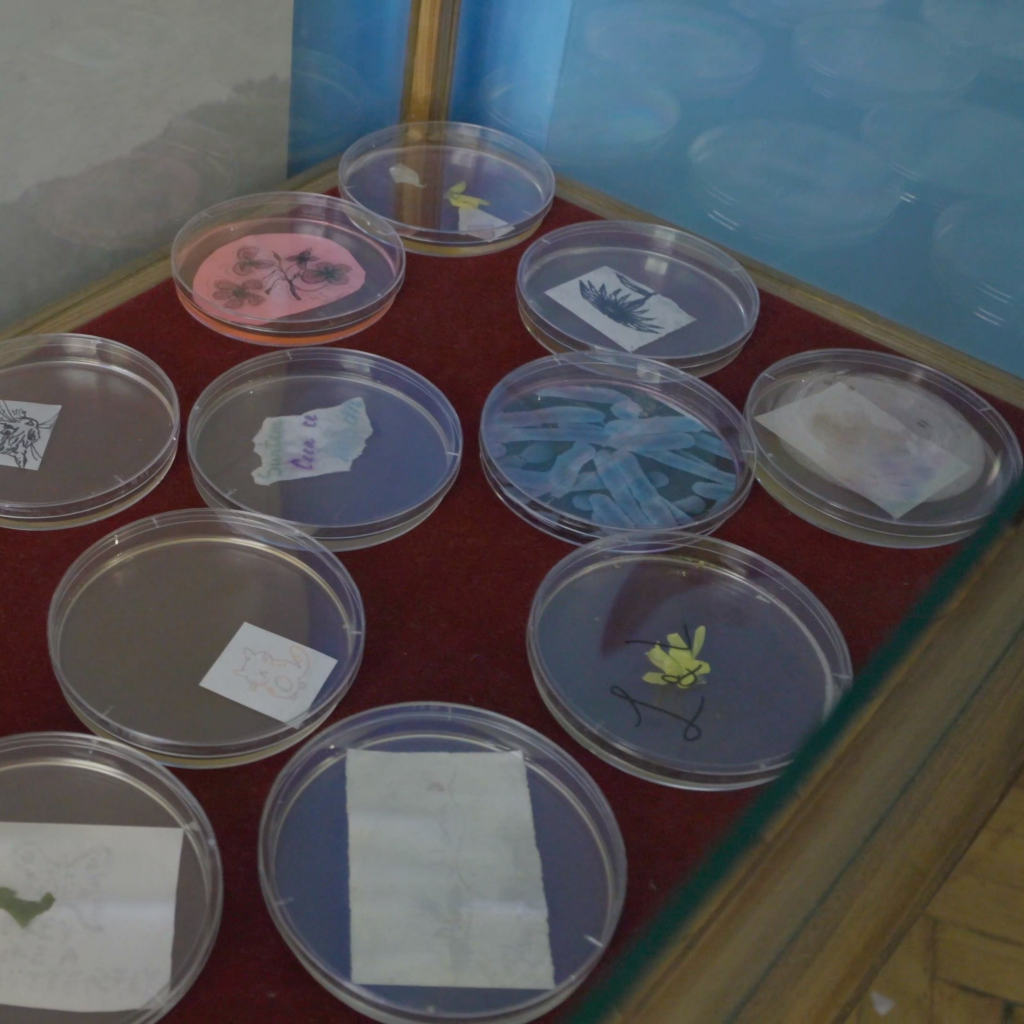
Semne de viata – Atelier bioarta

Proiectul Post-educația. Pedagogii ale crizei face parte din Programul Cultural Timișoara – Capitală Europeană a Culturii 2023.
Proiectul își propune să dezvolte un ecosistem cultural care să susțină educația în abordarea crizelor actuale (climatice, energetice, politice, epidemiologice etc.) și în crearea de strategii pentru un viitor sustenabil, prin valorificarea rolului critic și emancipativ al artei și cel inovativ al noilor tehnologii. În cadrul proiectului vom organiza o serie de evenimente deschise publicului larg printre care: conferința Post-educația în care vor fi invitați teoreticieni ai artei, filosofi, pedagogi etc., expoziții realizate de studenți și elevi din Arad, Timișoara și București, ateliere de idei organizate în aer liber, mai multe sesiuni de mediere culturală la Complexul Muzeal Arad și ateliere pedagogice pilot cu artiști din țară și străinătate.
Vor fi publicate: volumul Post-educația cu articole prezentate la conferința cu același nume; broșurile Pedagogii ale crizei și Next.Ed.Kit – ghiduri de practică pedagogică și mediere culturală, realizate ca urmare a atelierului teoretic Pedagogii ale crizei și prin implicarea organizației Time’s Up! din Linz. Sub îndrumarea lui DARV Collective din Linz vor fi realizate de către elevi și studenți arădeni lucrări artistice de realitate augmentată care vor putea fi regăsite prin intermediul aplicației de realitate augumentată în diverse locații din Arad.
Asociația Doar Mâine își propune să reitereze în viitor realizările din proiect care au avut impact asupra scenei artistice și publicului din Arad.